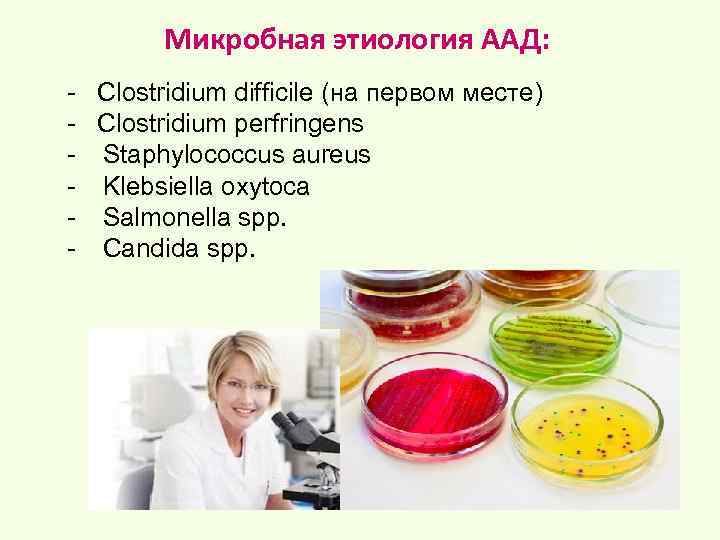

ДИАРЕЯ ИНФЕКЦИОННАЯ.pptx
- Количество слайдов: 43
 СИНДРОМ ДИАРЕИ В КЛИНИЧЕСКОЙ ПРАКТИКЕ ДИАРЕЯ ПУТЕШЕСТВЕННИКОВ д. м. н. , профессор Селиванова Галина Борисовна
СИНДРОМ ДИАРЕИ В КЛИНИЧЕСКОЙ ПРАКТИКЕ ДИАРЕЯ ПУТЕШЕСТВЕННИКОВ д. м. н. , профессор Селиванова Галина Борисовна
 Классификация диареи Неинфекционная вирусы - Норавирус - Кишечный аденовирус - Ротавирус - Астровирус - Коронавирус - Энтеровирус - Цитомегаловирус и др. Инфекционная бактерии - Salmonella - Энтеротоксигенная, энтерогеморрагическа я E. coli - Campylobacter - Shigella - Clostridium difficile и др. простейшие Giardia lamblia Entamoeba histolytica и др.
Классификация диареи Неинфекционная вирусы - Норавирус - Кишечный аденовирус - Ротавирус - Астровирус - Коронавирус - Энтеровирус - Цитомегаловирус и др. Инфекционная бактерии - Salmonella - Энтеротоксигенная, энтерогеморрагическа я E. coli - Campylobacter - Shigella - Clostridium difficile и др. простейшие Giardia lamblia Entamoeba histolytica и др.
 Синдром диареи, механизм развития Инфекционная диарея Неинфекционная диарея 1. Секреторная ↑ поступление хлоридов в просвет кишечника=> ↑поступление воды в просвет кишечника 2. Осмотическая возбудитель поражает ворсинку кишечника => нарушается ее функция => нарушается пищеварение в просвете кишки, накапливаются не переварившиеся углеводы => ↑ поступление воды в просвет кишечника 3. Воспалительная диарея максимально поражается толстый кишечник, поражается ее стенка => секреция белка в просвет кишечника, гноя, слизи, эритроцитов Часто встречается сочетанные формы!!!
Синдром диареи, механизм развития Инфекционная диарея Неинфекционная диарея 1. Секреторная ↑ поступление хлоридов в просвет кишечника=> ↑поступление воды в просвет кишечника 2. Осмотическая возбудитель поражает ворсинку кишечника => нарушается ее функция => нарушается пищеварение в просвете кишки, накапливаются не переварившиеся углеводы => ↑ поступление воды в просвет кишечника 3. Воспалительная диарея максимально поражается толстый кишечник, поражается ее стенка => секреция белка в просвет кишечника, гноя, слизи, эритроцитов Часто встречается сочетанные формы!!!
 Секреторная диарея, механизм развития (вирусы, энтеротоксигенная E. coli, Clostridium difficile, V. cholerae) V. cholerae Cholera toxin Na+ , H 2 O Cl CFTR G Protein c. AMP adenylate cyclase
Секреторная диарея, механизм развития (вирусы, энтеротоксигенная E. coli, Clostridium difficile, V. cholerae) V. cholerae Cholera toxin Na+ , H 2 O Cl CFTR G Protein c. AMP adenylate cyclase
 Осмотическая диарея, механизм (E. coli, Salmonella, Campylobacter, вирусы) Поражение ворсинок тонкой кишки (дистрофия, сглаживание) Сглаживание, облысение слизистой оболочки В основном страдает переваривание углеводов Притяжение воды в просвет кишки Обильный и частый стул с пузырьками газа
Осмотическая диарея, механизм (E. coli, Salmonella, Campylobacter, вирусы) Поражение ворсинок тонкой кишки (дистрофия, сглаживание) Сглаживание, облысение слизистой оболочки В основном страдает переваривание углеводов Притяжение воды в просвет кишки Обильный и частый стул с пузырьками газа
 Воспалительная диарея, механизм (E. coli, Salmonella, Clostridium difficile, Entamoeba histolytica) Инфильтрация стенки толстого к-ка, в просвет кишки секреция белка, в кале определяются слизь, гной , эритроциты. Shigella мигрирует через плотные контакты Инвазия Гибель эпителиальной клетки Размножение и внутриклеточное распространение Эпителиальная клетка M клетка PMN Макрофаг Лизис фагосом и апоптоз макрофагов IL Миграция воспалительных клеток в стенку кишечника
Воспалительная диарея, механизм (E. coli, Salmonella, Clostridium difficile, Entamoeba histolytica) Инфильтрация стенки толстого к-ка, в просвет кишки секреция белка, в кале определяются слизь, гной , эритроциты. Shigella мигрирует через плотные контакты Инвазия Гибель эпителиальной клетки Размножение и внутриклеточное распространение Эпителиальная клетка M клетка PMN Макрофаг Лизис фагосом и апоптоз макрофагов IL Миграция воспалительных клеток в стенку кишечника
 Клиническая картина - повышенная температура; - тошнота, рвота; - боль в животе; - диарея; - избыточное газообразование в кишечнике (метеоризм) Гастрит Энтерит Колит
Клиническая картина - повышенная температура; - тошнота, рвота; - боль в животе; - диарея; - избыточное газообразование в кишечнике (метеоризм) Гастрит Энтерит Колит
 Критерии тяжести кишечной инфекции Выраженность интоксикации и проявления гастроэнтероколита 1. Выраженность интоксикации и лихорадки (субфебрильная, высокая) 2. Рвота (однократная, повторная, неукротимая) 3. Диарея – (до 10 раз, до 11 -20 раз, более 20 раз в сутки), характер испражнений (наличие патологических примесей: слизи, крови) 4. Дегидратация (обезвоживание I-IV степени)
Критерии тяжести кишечной инфекции Выраженность интоксикации и проявления гастроэнтероколита 1. Выраженность интоксикации и лихорадки (субфебрильная, высокая) 2. Рвота (однократная, повторная, неукротимая) 3. Диарея – (до 10 раз, до 11 -20 раз, более 20 раз в сутки), характер испражнений (наличие патологических примесей: слизи, крови) 4. Дегидратация (обезвоживание I-IV степени)
 Диагностика - Серодиагностика (определение АТ в крови) - Выделение возбудителя - посев биологических сред (кровь, кал, моча, желчь)
Диагностика - Серодиагностика (определение АТ в крови) - Выделение возбудителя - посев биологических сред (кровь, кал, моча, желчь)
 Диарея путешественников • Диарея путешественников — полиэтиологический клинический синдром, который характеризуется 3 -х кратным или более частым появлением неоформленного стула в течение суток у людей, выезжающих за пределы своей страны или в другую климатогеографическую зону, в частности, у туристов.
Диарея путешественников • Диарея путешественников — полиэтиологический клинический синдром, который характеризуется 3 -х кратным или более частым появлением неоформленного стула в течение суток у людей, выезжающих за пределы своей страны или в другую климатогеографическую зону, в частности, у туристов.
 АКТУАЛЬНОСТЬ • Расстройство функции жкт наблюдается чаще в первые две недели после приезда. • В течение поездки до 75% туристов переносят один и более эпизодов диареи. • Диарея путешественников длится не более одной недели, но в 6– 10% случаев заболевание может длиться две недели и более.
АКТУАЛЬНОСТЬ • Расстройство функции жкт наблюдается чаще в первые две недели после приезда. • В течение поездки до 75% туристов переносят один и более эпизодов диареи. • Диарея путешественников длится не более одной недели, но в 6– 10% случаев заболевание может длиться две недели и более.
 Ареал распространения • • • Частота развития диареи зависит: от географической зоны пребывания, длительности нахождения, условий обитания (качества воды и характера питания), а также вида деятельности. Риск возникновения диареи при поездках в Латинскую Америку, Африку, Азию - от 20% до 75%. • При путешествии в Китай, Южную Африку, Израиль, Южную Европу, Россию - от 8% до 20%. • Низкий риск развития диареи (< 5%) - при поездках в США, Австралию, Японию, Канаду, страны Северной и Западной Европы, Новой Зеландии
Ареал распространения • • • Частота развития диареи зависит: от географической зоны пребывания, длительности нахождения, условий обитания (качества воды и характера питания), а также вида деятельности. Риск возникновения диареи при поездках в Латинскую Америку, Африку, Азию - от 20% до 75%. • При путешествии в Китай, Южную Африку, Израиль, Южную Европу, Россию - от 8% до 20%. • Низкий риск развития диареи (< 5%) - при поездках в США, Австралию, Японию, Канаду, страны Северной и Западной Европы, Новой Зеландии
 Эпидемиология ОКИ • Риск развития значительно повышается при поездках в тропические страны в период сезонных дождей и в летнее время. • Механизм передачи фекально-оральный. • Нарушения пищеварения могут быть связаны с изменением питания и режима быта на новом месте пребывания: другой солевой состав воды, сезонная пища, непривычные сорта мяса, резкая смена климата и высоты, стрессы, присущие переездам, покупка еды или воды у «уличных» торговцев.
Эпидемиология ОКИ • Риск развития значительно повышается при поездках в тропические страны в период сезонных дождей и в летнее время. • Механизм передачи фекально-оральный. • Нарушения пищеварения могут быть связаны с изменением питания и режима быта на новом месте пребывания: другой солевой состав воды, сезонная пища, непривычные сорта мяса, резкая смена климата и высоты, стрессы, присущие переездам, покупка еды или воды у «уличных» торговцев.
 Эпидемиология • Основные факторы передачи инфекции: • пищевые продукты, • вода и лед, • напитки. • Наибольшую опасность представляют: • салаты, овощи, фрукты с поврежденной кожурой, • холодные закуски, мясные продукты, недостаточно термически обработанные или сырые, • сырая или плохо прожаренная рыба, продукты моря, • непастеризованное молоко, • мороженое, молочные продукты.
Эпидемиология • Основные факторы передачи инфекции: • пищевые продукты, • вода и лед, • напитки. • Наибольшую опасность представляют: • салаты, овощи, фрукты с поврежденной кожурой, • холодные закуски, мясные продукты, недостаточно термически обработанные или сырые, • сырая или плохо прожаренная рыба, продукты моря, • непастеризованное молоко, • мороженое, молочные продукты.
 ЛЯМБЛИОЗ – кишечная инвазия с преимущественным поражением тонкой кишки - Возбудитель - лямблия (синонимы: Lamblia intestinalis; Lamblia duodenalis, Giardia lamblia, Giardia intestinalis) - По данным ВОЗ клиническими формами лямблиоза страдает 500 000 человек в год во всем мире 1 - В РФ ежегодно регистрируется более 100 000 человек, инфицированных лямблиями, при этом 90 % заболевших - это дети 1859 г - впервые описан в отечественным ученым Д. Ф. Лямблем 1. http: //medvestnik. ru/archive/ 2008/15/1459. html
ЛЯМБЛИОЗ – кишечная инвазия с преимущественным поражением тонкой кишки - Возбудитель - лямблия (синонимы: Lamblia intestinalis; Lamblia duodenalis, Giardia lamblia, Giardia intestinalis) - По данным ВОЗ клиническими формами лямблиоза страдает 500 000 человек в год во всем мире 1 - В РФ ежегодно регистрируется более 100 000 человек, инфицированных лямблиями, при этом 90 % заболевших - это дети 1859 г - впервые описан в отечественным ученым Д. Ф. Лямблем 1. http: //medvestnik. ru/archive/ 2008/15/1459. html
 Влияние лямблий на организм 1. Механическое, токсическое , нарушение кишечного всасывания, нарушение питания 2. Интоксикация, внекишечные проявления, иммунные реакции/ аллергия - Клинические проявления лямблиоза во многом обусловлены ухудшением всасывания, особенно жиров и углеводов. - Понижается активность ферментов (лактазы, энтеропептидазы и др. ), снижается абсорбция витамина B 12, нарушается С-витаминный обмен. - Вещества, продуцируемые лямблиями, прямо или косвенно повреждают структуру микроворсинок тонкой кишки.
Влияние лямблий на организм 1. Механическое, токсическое , нарушение кишечного всасывания, нарушение питания 2. Интоксикация, внекишечные проявления, иммунные реакции/ аллергия - Клинические проявления лямблиоза во многом обусловлены ухудшением всасывания, особенно жиров и углеводов. - Понижается активность ферментов (лактазы, энтеропептидазы и др. ), снижается абсорбция витамина B 12, нарушается С-витаминный обмен. - Вещества, продуцируемые лямблиями, прямо или косвенно повреждают структуру микроворсинок тонкой кишки.
 Течение лямблиоза 1. инкубационный период (1 - 4 недели) 2. период острых клинических проявлений (может отсутствовать) 3. период хронизации 4. период реконвалесценции Лямблии выстилают поверхность кишечника
Течение лямблиоза 1. инкубационный период (1 - 4 недели) 2. период острых клинических проявлений (может отсутствовать) 3. период хронизации 4. период реконвалесценции Лямблии выстилают поверхность кишечника
 ЛЯМБЛИОЗ: Клинические формы лямблиоза 1. 2. Лямблиоз без клинических проявлений (латентный - 55%, носительство - 20% 1) Лямблиоз с клиническими проявлениями (манифестный - 25%): Кишечная форма (функциональные расстройства кишечника, дуоденит, энтерит, гастроэнтерит, дуоденогастральный рефлюкс) Билиарно-панкреатическая форма (дискинезия желчевыводящих путей, диспанкреатизм, реактивный панкреатит) Форма с внекишечными проявлениями (нейроциркуляторная дистония, астеноневротический синдром, аллергические проявления) Смешанная форма (сочетание разных симптомов) 1. Данные ВОЗ (2002)
ЛЯМБЛИОЗ: Клинические формы лямблиоза 1. 2. Лямблиоз без клинических проявлений (латентный - 55%, носительство - 20% 1) Лямблиоз с клиническими проявлениями (манифестный - 25%): Кишечная форма (функциональные расстройства кишечника, дуоденит, энтерит, гастроэнтерит, дуоденогастральный рефлюкс) Билиарно-панкреатическая форма (дискинезия желчевыводящих путей, диспанкреатизм, реактивный панкреатит) Форма с внекишечными проявлениями (нейроциркуляторная дистония, астеноневротический синдром, аллергические проявления) Смешанная форма (сочетание разных симптомов) 1. Данные ВОЗ (2002)
 Дерматологические симптомы лямблиоза Кореподобная сыпь (у детей 1 -го года жизни); Крапивница (в т. ч. как реакция на солнечные лучи); Отек Квинке; Фолликулярный точечный кератоз; Неравномерная окраска кожи ( «разноцветная кожа» ), Иктеричность, Ксероз, ~ Синдром Эндрюса – чаще изолированное поражение ладоней и подошв; • Хейлит • •
Дерматологические симптомы лямблиоза Кореподобная сыпь (у детей 1 -го года жизни); Крапивница (в т. ч. как реакция на солнечные лучи); Отек Квинке; Фолликулярный точечный кератоз; Неравномерная окраска кожи ( «разноцветная кожа» ), Иктеричность, Ксероз, ~ Синдром Эндрюса – чаще изолированное поражение ладоней и подошв; • Хейлит • •
 ДИАГНОСТИКА 1. Анализы крови: эозинофилия, лимфоцитоз, при хроническом течении -гипохромная анемия 2. Эндоскопия: Атрофия слизистой оболочки, укорочение ворсинок, углубление крипт, лимфоцитарная инфильтрация, могут обнаруживаться лямблия
ДИАГНОСТИКА 1. Анализы крови: эозинофилия, лимфоцитоз, при хроническом течении -гипохромная анемия 2. Эндоскопия: Атрофия слизистой оболочки, укорочение ворсинок, углубление крипт, лимфоцитарная инфильтрация, могут обнаруживаться лямблия
 ДИАГНОСТИКА Для диагностики лямблиоза необходимо: • Исследование фекалий или дуоденального содержимого на лямблии • Серологическое исследование крови и кала с определением специфических антител 1. ИФА кала на определения антигена лямблий (чаще используется) • Исследование кала: микроскопия нативного мазка, окрашивании мазка раствором Люголя, с и использованием различных методов концентрации цист (методом механического обогащения или формалин-эфирного обогащения) • ПЦР кала
ДИАГНОСТИКА Для диагностики лямблиоза необходимо: • Исследование фекалий или дуоденального содержимого на лямблии • Серологическое исследование крови и кала с определением специфических антител 1. ИФА кала на определения антигена лямблий (чаще используется) • Исследование кала: микроскопия нативного мазка, окрашивании мазка раствором Люголя, с и использованием различных методов концентрации цист (методом механического обогащения или формалин-эфирного обогащения) • ПЦР кала
 Принципы лечения острых кишечных инфекций - Диета (вязкая протертая пища, сухари, каши, кисели, отвары, блюда из яичных белков - Регидротация (солевые растворы) - Антибиотики (чаще назначают при симптомах интоксикации, лихорадке, признаках генерализации инфекции (как можно более раннее назначение)) - Адсорбенты (смекта, активированный уголь, полисорб и т. д. ) - Бактериофаги - Про- и пребиотики - Ферменты
Принципы лечения острых кишечных инфекций - Диета (вязкая протертая пища, сухари, каши, кисели, отвары, блюда из яичных белков - Регидротация (солевые растворы) - Антибиотики (чаще назначают при симптомах интоксикации, лихорадке, признаках генерализации инфекции (как можно более раннее назначение)) - Адсорбенты (смекта, активированный уголь, полисорб и т. д. ) - Бактериофаги - Про- и пребиотики - Ферменты
 ЭТИОТРОПНАЯ ТЕРАПИЯ ОКИ 1. Средства, обеспечивающие - антимикробный эффект практически только в кишечнике, не оказывают резорбитивного 2. Препараты системного действия (кишечные антисептики): действия (хорошо всасываются производные 5 -нитрофурана; из тонкой к-ки, оказывают производные 8 -оксихинолона; системное действие, нефторированные хинолоны; одновременно достигают производные сульфаниламида терапевтических концентраций в содержимом кишечника): - фторхинолоны; - бета-лактамазы, тетрациклины; - производные сульфаниламида; - аминогликозиды; - 5 -нитроимидазолы, - макролиды и др.
ЭТИОТРОПНАЯ ТЕРАПИЯ ОКИ 1. Средства, обеспечивающие - антимикробный эффект практически только в кишечнике, не оказывают резорбитивного 2. Препараты системного действия (кишечные антисептики): действия (хорошо всасываются производные 5 -нитрофурана; из тонкой к-ки, оказывают производные 8 -оксихинолона; системное действие, нефторированные хинолоны; одновременно достигают производные сульфаниламида терапевтических концентраций в содержимом кишечника): - фторхинолоны; - бета-лактамазы, тетрациклины; - производные сульфаниламида; - аминогликозиды; - 5 -нитроимидазолы, - макролиды и др.
 Требования к оптимальному антибактериальному препарату для лечения диареи не должен всасываться из ЖКТ не должен подавлять нормофлору должен создавать высокую концентрацию в полости кишки должен иметь широкий спектр действия должен иметь минимум побочных эффектов должен иметь доказанную эффективность
Требования к оптимальному антибактериальному препарату для лечения диареи не должен всасываться из ЖКТ не должен подавлять нормофлору должен создавать высокую концентрацию в полости кишки должен иметь широкий спектр действия должен иметь минимум побочных эффектов должен иметь доказанную эффективность
 Осложнения ОКИ • Дисбактериоз кишечника • После перенесенного ОКИ у 3– 10% больных развивается СРК: • боли в животе, • дискомфорт, • неустойчивый стул (периоды диареи и запоры), • вздутие, метеоризм, боли во время акта дефекации. • В условиях жаркого климата быстро развиваются признаки обезвоживания (1– 4 степени).
Осложнения ОКИ • Дисбактериоз кишечника • После перенесенного ОКИ у 3– 10% больных развивается СРК: • боли в животе, • дискомфорт, • неустойчивый стул (периоды диареи и запоры), • вздутие, метеоризм, боли во время акта дефекации. • В условиях жаркого климата быстро развиваются признаки обезвоживания (1– 4 степени).
 Дисбактериоз. СИБР. Нормальное содержание бактериальной флоры тонкой кишки в 1 мл Микроорганизмы Желудок Тощая кишка Подвздошная кишка Слепая кишка Общее количество бактерий 0 -10 3 0 -10 4 10 5 -10 9 10 10 -10 11 Аэробы и факультативные анаэробы 0 -10 3 0 -10 4 10 2 -10 5 10 2 -10 9 0 0 10 3 -10 7 10 9 -10 12 Анаэробы С. Gregg, Ph. Toskes, 2002
Дисбактериоз. СИБР. Нормальное содержание бактериальной флоры тонкой кишки в 1 мл Микроорганизмы Желудок Тощая кишка Подвздошная кишка Слепая кишка Общее количество бактерий 0 -10 3 0 -10 4 10 5 -10 9 10 10 -10 11 Аэробы и факультативные анаэробы 0 -10 3 0 -10 4 10 2 -10 5 10 2 -10 9 0 0 10 3 -10 7 10 9 -10 12 Анаэробы С. Gregg, Ph. Toskes, 2002
 СИБР и дисбактериоз кишечника. Сходства и различия. Признаки СИБР Дисбактериоз Уровень поражения Тонкий кишечник Толстый кишечник Причинноследственная связь Развивается на фоне других заболеваний Считается причиной других заболеваний Клиника Характерная Диагностика Достоверная Нет специфичной клиники Сомнительная
СИБР и дисбактериоз кишечника. Сходства и различия. Признаки СИБР Дисбактериоз Уровень поражения Тонкий кишечник Толстый кишечник Причинноследственная связь Развивается на фоне других заболеваний Считается причиной других заболеваний Клиника Характерная Диагностика Достоверная Нет специфичной клиники Сомнительная
 СИБР – повышение содержания бактерий в тонкой кишке 10 11 / мл с изменением бактериального спектра со сдвигом в сторону грамотрицательных и анаэробных штаммов Клиника - Диарея - Стеаторея - Гипопротеинемия - Анемия - Снижение веса - Астенизация - Признаки дефицита витаминов: Е (нейропатия), К (коагулопатия), D (остеомаляция)
СИБР – повышение содержания бактерий в тонкой кишке 10 11 / мл с изменением бактериального спектра со сдвигом в сторону грамотрицательных и анаэробных штаммов Клиника - Диарея - Стеаторея - Гипопротеинемия - Анемия - Снижение веса - Астенизация - Признаки дефицита витаминов: Е (нейропатия), К (коагулопатия), D (остеомаляция)
 Диагностика СИБР - Посев дуоденального содержимого (> 10 6 /мл) - Дыхательные тесты с Н 2 - С лактулозой - С глюкозой - С 14 С- ксилозой - С 14 С- гликохолатом
Диагностика СИБР - Посев дуоденального содержимого (> 10 6 /мл) - Дыхательные тесты с Н 2 - С лактулозой - С глюкозой - С 14 С- ксилозой - С 14 С- гликохолатом
 Дисбактериоз кишечника Клинико-лабораторный синдром, связанный с изменением качественного и/или количественного состава микрофлоры кишечника с последующим развитием метаболических и иммунологических нарушений с возможным развитием желудочно-кишечных расстройств ОСТ 91500. 11. 004 -2003
Дисбактериоз кишечника Клинико-лабораторный синдром, связанный с изменением качественного и/или количественного состава микрофлоры кишечника с последующим развитием метаболических и иммунологических нарушений с возможным развитием желудочно-кишечных расстройств ОСТ 91500. 11. 004 -2003
 Антибиотикоассоциированная диарея (ААД): три или более эпизодов неоформленного стула в течение двух или более последовательных дней, развившихся на фоне или в течение 2 месяцев после применения антибактериальных препаратов
Антибиотикоассоциированная диарея (ААД): три или более эпизодов неоформленного стула в течение двух или более последовательных дней, развившихся на фоне или в течение 2 месяцев после применения антибактериальных препаратов
 Частота встречаемости ААД на фоне антибиотиков: Антибиотик Частота возникновения, % Ампициллин 5 -10 Амоксиклав 10 -25 Цефиксим 15 -20 Другие цефалоспорины 2 -5 Макролиды 2 -5 Фторхинолоны 2 Клиндамицин, линкомицин 20 -30 Костюкевич О. И. , РМЖ, Клинические рекомендации и алгоритмы для практикующих врачей, Антибиотикоассоциированная диарея: мифы и реальность, 2009, № 7
Частота встречаемости ААД на фоне антибиотиков: Антибиотик Частота возникновения, % Ампициллин 5 -10 Амоксиклав 10 -25 Цефиксим 15 -20 Другие цефалоспорины 2 -5 Макролиды 2 -5 Фторхинолоны 2 Клиндамицин, линкомицин 20 -30 Костюкевич О. И. , РМЖ, Клинические рекомендации и алгоритмы для практикующих врачей, Антибиотикоассоциированная диарея: мифы и реальность, 2009, № 7
 Причины диареи, развивающейся после применения антибиотиков: - Аллергические, токсические и фармакологические побочные эффекты собственно антибиотиков; - Осмотическая диарея в результате нарушения метаболизма желчных кислот и углеводов в кишечнике; - Изменения микрофлоры кишечника.
Причины диареи, развивающейся после применения антибиотиков: - Аллергические, токсические и фармакологические побочные эффекты собственно антибиотиков; - Осмотическая диарея в результате нарушения метаболизма желчных кислот и углеводов в кишечнике; - Изменения микрофлоры кишечника.
Микробная этиология ААД: - Clostridium difficile (на первом месте) - Clostridium perfringens - Staphylococcus aureus - Klebsiella oxytoca - Salmonella spp. - Candida spp.
Микробная этиология ААД: - Clostridium difficile (на первом месте) - Clostridium perfringens - Staphylococcus aureus - Klebsiella oxytoca - Salmonella spp. - Candida spp.

 Восстановление микрофлоры кишечника Пробиотики, пребиотики, синбиотики • ПРОБИОТИКИ препараты, содержащие микроорганизмы. • Лечебный эффект развивается вследствие заселения кишечника микроорганизмами, поступающими в составе лекарственной форме. • ПРЕБИОТИКИ - препараты, содержащие компоненты питательной среды или вещества, поддерживающие выживание бактерий в просвете кишечника. СИНБИОТИКИ - препараты, полученные в результате рациональной комбинации пробиотиков и пребиотиков. Часто это БАДы, входящие в состав функционального питания, обогащенные одним или несколькими штаммами Lactobacillus и/или Bifidobacterium.
Восстановление микрофлоры кишечника Пробиотики, пребиотики, синбиотики • ПРОБИОТИКИ препараты, содержащие микроорганизмы. • Лечебный эффект развивается вследствие заселения кишечника микроорганизмами, поступающими в составе лекарственной форме. • ПРЕБИОТИКИ - препараты, содержащие компоненты питательной среды или вещества, поддерживающие выживание бактерий в просвете кишечника. СИНБИОТИКИ - препараты, полученные в результате рациональной комбинации пробиотиков и пребиотиков. Часто это БАДы, входящие в состав функционального питания, обогащенные одним или несколькими штаммами Lactobacillus и/или Bifidobacterium.
 Таргетные пробиотики (пробиотики направленного действия) üСодержат различные штаммы различных видов бактерий, üОбъединяют разные штаммы со схожими свойствами, üСпособности разных штаммов синергично направлены на решение конкретной проблемы
Таргетные пробиотики (пробиотики направленного действия) üСодержат различные штаммы различных видов бактерий, üОбъединяют разные штаммы со схожими свойствами, üСпособности разных штаммов синергично направлены на решение конкретной проблемы
 Отбор штаммов для влияния на факторы развития ААД • Cl. difficile выявляется- 20% всех случаев клинических проявлений • Cl. difficile НЕ выявляется - до 80% всех случаев клинических проявлений Разные штаммы проявляют различную антагонистическую активность в отношении патогенных микроорганизмов
Отбор штаммов для влияния на факторы развития ААД • Cl. difficile выявляется- 20% всех случаев клинических проявлений • Cl. difficile НЕ выявляется - до 80% всех случаев клинических проявлений Разные штаммы проявляют различную антагонистическую активность в отношении патогенных микроорганизмов
 Способность различных штаммов бактерий подавлять рост микроорганизмов, ассоциированных с кишечными расстройствами, вызванными приемом АБП Bifidobacterium bifidum W 23 Bifidobacterium lactis W 51 Lactobacillus acidophilus W 37 Lactobacillus acidophilus W 55 Lactobacillus paracasei W 20 Lactobacillus plantarum W 62 Lactobacillus rhamnosus W 71 Lactobacillus salivarius W 24 3 2. 5 2 1. 5 1 0. 5 an s m er lo P. ag g Sa lm on el la lla ige Sh is fa ec E. en ng fri er. p Cl al s s bt ilu su B. E. co li 0
Способность различных штаммов бактерий подавлять рост микроорганизмов, ассоциированных с кишечными расстройствами, вызванными приемом АБП Bifidobacterium bifidum W 23 Bifidobacterium lactis W 51 Lactobacillus acidophilus W 37 Lactobacillus acidophilus W 55 Lactobacillus paracasei W 20 Lactobacillus plantarum W 62 Lactobacillus rhamnosus W 71 Lactobacillus salivarius W 24 3 2. 5 2 1. 5 1 0. 5 an s m er lo P. ag g Sa lm on el la lla ige Sh is fa ec E. en ng fri er. p Cl al s s bt ilu su B. E. co li 0
 Профилактика ОКИ • соблюдение правил личной гигиены и пищевого режима в поездках, • избегать употребления пищи, купленной у уличных торговцев (наиболее опасны салаты и холодные закуски), • избегать употребления недостаточно термически обработанного мяса, морепродуктов, непастеризованных молочных продуктов, водопроводной воды, льда, овощей и фруктов, вымытых такой водой.
Профилактика ОКИ • соблюдение правил личной гигиены и пищевого режима в поездках, • избегать употребления пищи, купленной у уличных торговцев (наиболее опасны салаты и холодные закуски), • избегать употребления недостаточно термически обработанного мяса, морепродуктов, непастеризованных молочных продуктов, водопроводной воды, льда, овощей и фруктов, вымытых такой водой.
 Профилактика ОКИ • Не рекомендуется чистить зубы водопроводной водой. • В поездках лучше употреблять чай, кофе, бутилированную воду, • отдавать предпочтение фруктам, которые можно очищать и есть (снижается риск попадания возбудителей заболевания, которые могут находиться на кожуре).
Профилактика ОКИ • Не рекомендуется чистить зубы водопроводной водой. • В поездках лучше употреблять чай, кофе, бутилированную воду, • отдавать предпочтение фруктам, которые можно очищать и есть (снижается риск попадания возбудителей заболевания, которые могут находиться на кожуре).
 АПТЕЧКА ПУТЕШЕСТВЕННИКА 1. 2. 3. 4. 5. 6. АБ/кишечные антисептики. Антациды Ферменты Спазмолитики Жаропонижающие Пробиотики
АПТЕЧКА ПУТЕШЕСТВЕННИКА 1. 2. 3. 4. 5. 6. АБ/кишечные антисептики. Антациды Ферменты Спазмолитики Жаропонижающие Пробиотики
 СПАСИБО ЗА ВНИМАНИЕ!
СПАСИБО ЗА ВНИМАНИЕ!


